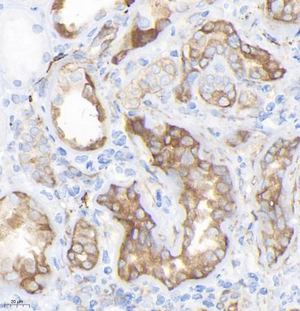
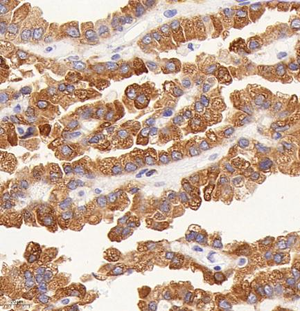

Anti-beta Tubulin Mouse mAb
- 50 μL
Product Information
Protein full name | Tubulin beta-3 chain |
Gene Id | 10381 |
Immunogen | Synthesized peptide derived from human TUBB3 |
Uniprot ID | Q13509 |
Source | Mouse |
Concentration | 1 mg/ml |
Purity | The antibody was affinity-purified from mouse ascites by affinity-chromatography using specific immunogen. |
Applications
IHC/IF | Human | 1: 200-1: 500 | kindey, renal carcinoma |
Background
TUBB3, the class III β tubulin or Tuj1, is selectively expressed in testis and neurons of the central and peripheral nervous system. It has been widely used as a marker for neurons. Aberrant expression of TUBB3 has also been found in various tumors of non-neural origin and can be used as a biomarker for cancer aggressiveness and a marker for the tendency to respond poorly to chemotherapy. This antibody is specific to TUBB3 but not cross-react with other tubulin isoforms.
Images
| Immunohistochemistry analysis of paraffin embedded human kindey using β-tubulin (GB14163) at dilution of 1: 200 |
| Immunohistochemistry analysis of paraffin embedded human renal carcinoma using β-tubulin (GB14163) at dilution of 1: 200 |
Storage
| Storage | Store at -20 ℃ for one year. Avoid repeated freeze/thaw cycles. |
| Storage Buffer | Liquid in PBS containing 50% glycerol, 0.5% BSA and 0.02% sodium azide. |
NOTE:
1.This product is intended for research only.
2.This product is recommended to dilute with the Primary Antibody Dilution Buffer (G2025).
| 货号 | 名称 | 规格 | 价格 | 操作 |
|---|
| 货号 | 名称 | 规格 | 价格 | 操作 |
|---|